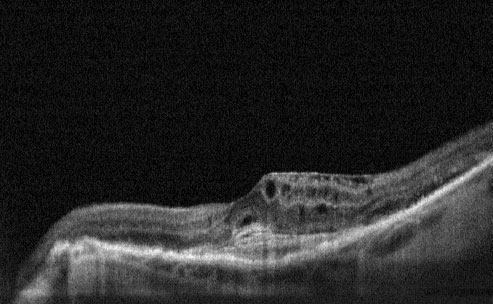
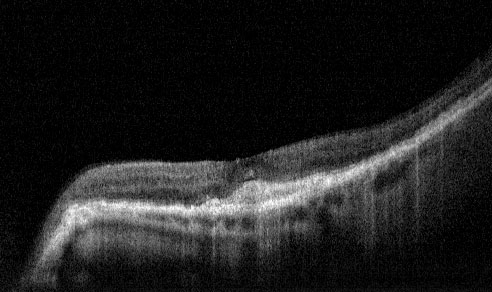

FAQs
The dry form has early and intermediate stages. Does the wet form have similar stages?
No. The wet form is considered advanced AMD .
Can advanced AMD be either the dry form or the wet form?
Yes. Both the wet form and the advanced dry form are considered advanced AMD . Vision loss occurs with either form. In most cases, only advanced AMD can cause vision loss.
People who have advanced AMD in one eye are at especially high risk of developing advanced AMD in the other eye. Which is more common--the dry form or the wet form?
The dry form is much more common. More than 85 percent of all people with intermediate and advanced AMD combined have the dry form.
However, if only advanced AMD is considered, about two-thirds of patients have the wet form. Because almost all visual acuity loss comes from advanced AMD, the wet form leads to significantly more vision loss than the dry form.
Can the dry form turn into the wet form?
Yes. All people who have the wet form had the dry form first. The dry form can advance and cause vision loss without turning into the wet form. The dry form also can suddenly turn into the wet form, even during early stage AMD . There is no way to tell if or when the dry form will turn into the wet form.
Who is at risk for AMD?
AMD can occur during middle age. The risk increases with aging. Other risk factors include:
▪ Smoking.
▪ Obesity. Research studies suggest a link between obesity and the progression of early and intermediate stage AMD to advanced AMD .
▪ Race. Whites are much more likely to lose vision from AMD than African Americans.
▪ Family history. People with a family history of AMD are at higher risk of getting the disease.
▪ Gender. Women appear to be at greater risk than men.
How is AMD detected?
AMD is detected during a comprehensive eye exam that includes:
▪ Visual acuity test. This eye chart test measures how well you see at various distances.
▪ Dilated eye exam. Drops are placed in your eyes to widen, or dilate, the pupils. Your eye care professional uses a special magnifying lens to examine your retina and optic nerve for signs of AMD and other eye problems.
▪ Retinal Scan using OCT
▪ Colour fundus photo to permanently record fundus image
▪ Optional fluorescein angiogram dependent on other examinations
Treatment
The major treatments for wet AMD are:
Anti VEGF therapy with either LUCENTIS or AVASTIN / PDT / Laser / Lucentis ® (Ranibizumab) Anti VEGF Therapy.
Research has identified a molecule that plays a pivotal role in the growth of abnormal blood vessels inside the eye. This molecule is called 'vascular endothelial growth factor' or VEGF and in addition to promoting new vessel growth it also has the ability to make otherwise healthy retinal blood vessels very "leaky" thus leading to retinal swelling (macular oedema). Such changes, brought about by high levels of VEGF can be halted or reversed by blocking the action of VEGF.
Lucentis is an antibody fragment that inactivates all active forms of VEGF. Lucentis has the benefit of a rigorous and exhaustive research database to support its use in Wet AMD .
The M.A.R.I.N.A study was a clinical trial that showed 95% of patients with Wet AMD receiving four weekly Lucentis injections experienced visual stability. Up to 40% of Lucentis treated patients actually showed vision improvement amounting to a doubling of the resolution of the eye. For comparison, previous therapies including Photodynamic therapy for Wet AMD usually show such levels of vision improvement occurring in around 5% of patients. This gives an indication of the real leap in therapy for Wet AMD that Lucentis represents.
Safety data from the M.A.R.I.N.A study showed infection occurring in around 0.6% of patients after twelve months of therapy. There are ongoing studies investigating the effectiveness of using a lower frequency of drug administration, one injection per four weeks followed by an injection every three months thereafter until final stabilisation. The results of this less intensive therapeutic approach for Lucentis are likely to be published shortly. Until this data is available it is reasonable to undergo injections on a four weekly basis for at least six months before considering the reduced frequency. It may also be possible to combine the Lucentis injections with Photodynamic therapy to try and achieve a more rapid stabilisation of the Wet AMD and to limit the overall duration of the treatment program.
Site Design: www.hartydesign.com
Home | About Ocular Imaging | Contact | Eye Diseases | Prevention | Technology | Links | FAQs
©2010 Ocular Imaging
Pre-Treatment- Cystoid Macular Oedema and CNV
Avastin ® (Bevacizumab)
Anti VEGF Therapy.
Avastin is the parent molecule of Lucentis. Where Lucentis is the antibody fragment, Avastin is the whole antibody. Avastin is licensed as cancer therapy in patients with advanced lower bowel cancer. The close similarity of the Avastin molecule to the Lucentis molecule prompted Ophthalmologists to use Avastin for Wet AMD . Their positive experiences led to a rapid acceptance by many macular degeneration specialists that Avastin has an important role to play in treating patients with wet AMD .
Numerous studies have used a tiny fraction of the normal dose used for patients with bowel cancers, given directly into the eye in the same way as Macugen and Lucentis. One recent report showed dramatic clinical improvement after just one injection in around 40% of eyes together with a very significant average vision improvement in a group of 79 patients. There are now numerous individual case studies and case series published supporting the safety and effectiveness of Avastin in Wet AMD and other conditions such as retinal vein occlusion.
At present there are no large scale clinical trials for Avastin in Wet AMD . Avastin is therefore used as an "off label" therapy for Wet AMD in the UK. Currently there is an NHS trial underway directly comparing the efficacy of Avastin versus Lucentis (IVAN Study). Until this is complete it is difficult to foresee a position in which local primary care trusts would be likely to fund the costs of Avastin treatment on the NHS without prior NICE approval.
Post Treatment - 1 month following Lucentis Injection